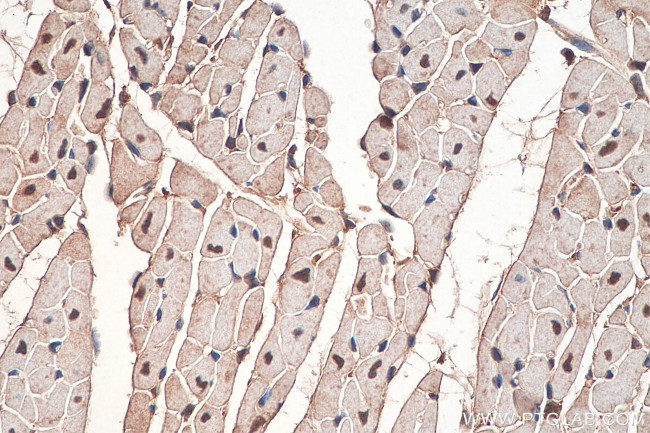
APOBEC2 Antibody in Immunohistochemistry (Paraffin) (IHC (P))

Search
Proteintech
APOBEC2 Polyclonal Antibody
{{$productOrderCtrl.translations['antibody.pdp.commerceCard.promotion.promotions']}}
{{$productOrderCtrl.translations['antibody.pdp.commerceCard.promotion.viewpromo']}}
{{$productOrderCtrl.translations['antibody.pdp.commerceCard.promotion.promocode']}}: {{promo.promoCode}} {{promo.promoTitle}} {{promo.promoDescription}}. {{$productOrderCtrl.translations['antibody.pdp.commerceCard.promotion.learnmore']}}
产品信息
20121-1-AP
种属反应
宿主/亚型
分类
类型
抗原
偶联物
形式
浓度
规格
纯化类型
保存液
内含物
保存条件
运输条件
产品详细信息
Immunogen sequence: MAQKEEAAV ATEAASQNGE DLENLDDPEK LKELIELPPF EIVTGERLPA NFFKFQFRNV EYSSGRNKTF LCYVVEAQGK GGQVQASRGY LEDEHAAAHA EEAFFNTILP AFDPALRYNV TWYVSSSPCA ACADRIIKTL SKTKNLRLLI LVGRLFMWEE PEIQAALKKL KEAGCKLRIM KPQDFEYVWQ NFVEQEEGES KAFQPWEDIQ ENFLYYEEKL ADILK (1-224 aa encoded by BC047767)
靶标信息
APOBEC2 belongs to the cytidine and deoxycytidylate deaminase family. It is probable C to U editing enzyme whose physiological substrate is not yet known. It does not display detectable apoB mRNA editing and has a low intrinsic cytidine deaminase activity.
仅用于科研。不用于诊断过程。未经明确授权不得转售。
生物信息学
蛋白别名: apolipoprotein B editing complex 2; apolipoprotein B mRNA editing enzyme, catalytic polypeptide 2; apolipoprotein B mRNA editing enzyme, catalytic polypeptide-like 2; C->U-editing enzyme APOBEC-2; mRNA(cytosine(6666)) deaminase 2; OTTHUMP00000039773; probable C->U-editing enzyme APOBEC-2; similar to APOBEC-1; unnamed protein product
基因别名: APOBEC2; ARCD1; ARP1
UniProt ID: (Human) Q9Y235, (Mouse) Q9WV35
Entrez Gene ID: (Human) 10930, (Rat) 301226, (Mouse) 11811